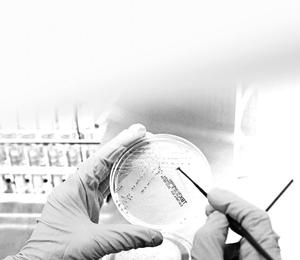

Más leídas
Opinión | Pág. 2
Sensibilización sobre el cáncer de mama
Opinión | Pág. 2
Declaran estado de emergencia

Opinión | Pág. 2
Reflexión
Opinión | Pág. 2
En jaque está el boleto integrado

Opinión | Pág. 2
El "Argonauta" en Talcahuano
Opinión | Pág. 2
Correo

Opinión | Pág. 2
Sobran razones

Actualidad | Pág. 4
Diputada Muñoz lidera reuniones virtuales por el Rechazo

Actualidad | Pág. 4
Servel alista logística para plebiscito y detalla protocolo de vocales de mesa

Actualidad | Pág. 4
Manifestaciones terminan con detenciones y desórdenes en el centro
Defunciones | Pág. 17
OBITUARIOS
Defunciones | Pág. 17
IN MEMORIAM

Actualidad | Pág. 3
Brotes en provincias de Arauco y Biobío provocan alza de casos activos de covid-19 en la Región

Actualidad | Pág. 3
Región suma 39 establecimientos que postulan a obtener sello Bicentenario
Actualidad | Pág. 3
SALUD NO INGRESÓ 60 CASOS POR FALLA DE REGISTRO

Actualidad | Pág. 3
Destacan estrategias destinadas a la detección del cáncer de mama

Espectáculos | Pág. 20
Versión de "Escénika" 2020 busca atraer en forma remota
Espectáculos | Pág. 20
Correo

Espectáculos | Pág. 20
Ricardo Monserrat: con Chile en el corazón

Actualidad | Pág. 5
Arrestan a hombre que integraba banda dedicada los "portonazos"

Actualidad | Pág. 5
Corte ordena a servicios públicos tomar medidas para sector "Las Monjas"

Actualidad | Pág. 5
Indagan origen de incendio que destruye cuarta escuela en la Provincia de Arauco
Actualidad | Pág. 5
Mañana formalizarán a sujeto por secuestros y abuso sexual
Actualidad | Pág. 5
Bomberos aborda protocolos por violencia

Economía y empresas | Pág. 10
Sence y Duoc UC capacitan a 120 microempresarios

Economía y empresas | Pág. 10
Comerciantes esperan recuperar 50% de ventas tras fin de cuarentena total

Economía y empresas | Pág. 10
Autoridades y dirigentes gremiales visitan obra para sensibilizar sobre cáncer de mama

Espectáculos | Pág. 19
Los cines de todo el mundo se asoman al abismo debido a la pandemia del covid-19

Espectáculos | Pág. 19
Armando Manzanero: "Estoy siendo premiado por la vida"
Espectáculos | Pág. 19
Enrique Iglesias: "Top Artist of All Time"
Espectáculos | Pág. 19
Comenzó juicio por la filiación de los hijos de Miguel Bosé y expareja

Espectáculos | Pág. 19
Actriz reveló que mantiene temor por la secta que esclavizó a su hija

Tendencias | Pág. 11
Descubren cómo el melanoma "engaña" al sistema inmunológico

Deportes | Pág. 13
Lamparita inicia campaña de abonado especial mientras espera el vamos de 3ª A

Tendencias | Pág. 11
El aceite de coco destruye el virus de covid-19, según científicos filipinos

Tendencias | Pág. 11
Encuentran muestra viva de coronavirus en embalaje de bacalao congelado

Deportes | Pág. 13
Huachipato apunta a Unión La Calera y mira de reojo sorteo de Copa Sudamericana

Deportes | Pág. 13
La "Maquinita" apuesta por Claudio Rojas para enderezar su rumbo hacia al ascenso

Nacional | Pág. 6
Convocantes a marchas "serán responsables si hay un brote"

Nacional | Pág. 6
Alcalde Alessandri critica al Estado por no haber sido capaz de contener la violencia
Nacional | Pág. 6
Positividad en la capital llegó al 3%

Deportes | Pág. 14
La "U" busca reforzar al plantel con otro conocido de Caputto

Deportes | Pág. 14
Sánchez sigue siendo la mayor duda de Conte para el debut en Champions

Deportes | Pág. 14
Un autogol acaba con el invicto de local de Leeds en la Premier League

Deportes | Pág. 14
VAR valida penal en favor de la UC en partido suspendido contra Curicó

Deportes | Pág. 14
Colo Colo va por su paso a los octavos de la Libertadores con la atención puesta en Montevideo

Nacional | Pág. 8
Carlos Mesa reconoce el triunfo de Luis Arce en Bolivia

Nacional | Pág. 8
Trump llama "idiota" a Fauci y amenaza con despedirlo

Nacional | Pág. 8
Suecia evalúa confinamiento y el mundo suma 40,5 millones casos
Nacional | Pág. 8
OMS dice que el mundo está cansado de luchar

Página del lector | Pág. 18
Aviones

Página del lector | Pág. 18
Fotoclick!

Página del lector | Pág. 18
Horóscopo

Página del lector | Pág. 18
Crucigrama

Página del lector | Pág. 18
Sudoku